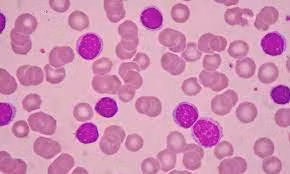
Thuốc tấn công các ty thể bị suy yếu có thể là một cách đầy hứa hẹn để tiêu diệt tế bào ung thư.

Các ứng viên thuốc có khả năng vô hiệu hóa những ty thể bị lỗi trong tế bào ung thư. Chúng cũng có hiệu quả hơn nhiều khi kết hợp với các loại thuốc hóa trị hiện có. Nghiên cứu đã được công bố trên tạp chí Leukemia.
Ty thể là những cấu trúc nhỏ bên trong tế bào có chức năng sản xuất năng lượng. Theo thời gian, chúng có thể bị hư hỏng. Vì vậy, các tế bào phá vỡ những ty thể cũ thông qua một quá trình được gọi là “mitophagy”.
Thuốc tấn công các ty thể bị suy yếu có thể là một cách đầy hứa hẹn để tiêu diệt tế bào ung thư, mà không làm tổn hại nhiều đến tế bào khỏe mạnh. Trong nghiên cứu mới, các nhà khoa học tại Trường Đại học Rice và Đại học Texas ở Austin (Mỹ) đã kiểm tra 8 hợp chất nhắm vào ty thể.
Natasha Kirienko - tác giả nghiên cứu cho biết: “Giả thuyết là nếu quá trình mitophagy được kích hoạt, các tế bào bệnh bạch cầu có thể thực sự gặp nguy hiểm.
Chúng tôi phát hiện, sáu trong số 8 hợp chất phân tử nhỏ có thể tiêu diệt các tế bào bệnh bạch cầu. Chúng tôi muốn nghiên cứu sâu hơn và đã xem xét các phân tử có liên quan”.
Nhóm nghiên cứu đã xác định được 30 phân tử tương tự ở mỗi loại hợp chất. Sau đó, họ kiểm tra mức độ độc hại của chúng đối với các tế bào bệnh bạch cầu, dù đơn lẻ hay kết hợp với những loại thuốc hiện có.
Ở thử nghiệm trong nuôi cấy tế bào, sáu trong số các hợp chất được tìm thấy có hiệu quả trong việc tiêu diệt bệnh bạch cầu cấp dòng tủy (AML) - dạng bệnh phổ biến nhất. Năm trong số sáu loại đó cũng có hiệu quả chống lại hai dạng bệnh khác là bạch cầu lymphocytic cấp tính (ALL) và bạch cầu kinh dòng tủy (CML).
Khi kết hợp với thuốc hóa trị doxorubicin, một hợp chất mới tên PS127B được phát hiện hoạt động tốt hơn nhiều so với các phương pháp điều trị hiện tại. Một hệ số thường được dùng để mô tả hiệu quả khi kết hợp hai loại thuốc với nhau.
Doxorubicin và cytarabine, một tổ hợp thường được sử dụng để điều trị bệnh bạch cầu, có hệ số tổng hợp là 13. Trong khi đó, doxorubicin và PS127B có hệ số đáng kinh ngạc là 29.
Các thử nghiệm sâu hơn trên chuột với các tế bào ung thư được cấy ghép lấy từ bệnh nhân ung thư bạch cầu ở người cho thấy, một hợp chất khác - PS127E cũng đặc biệt hiệu quả.
Điều quan trọng là, những loại thuốc này gây ra tác hại tối thiểu cho các tế bào khỏe mạnh. Mặc dù đầy hứa hẹn, nhưng nghiên cứu vẫn đang trong giai đoạn đầu. Các nhà nghiên cứu cho biết, cần phải thực hiện nhiều công việc hơn nữa trước khi thuốc có thể được thử nghiệm trên người.